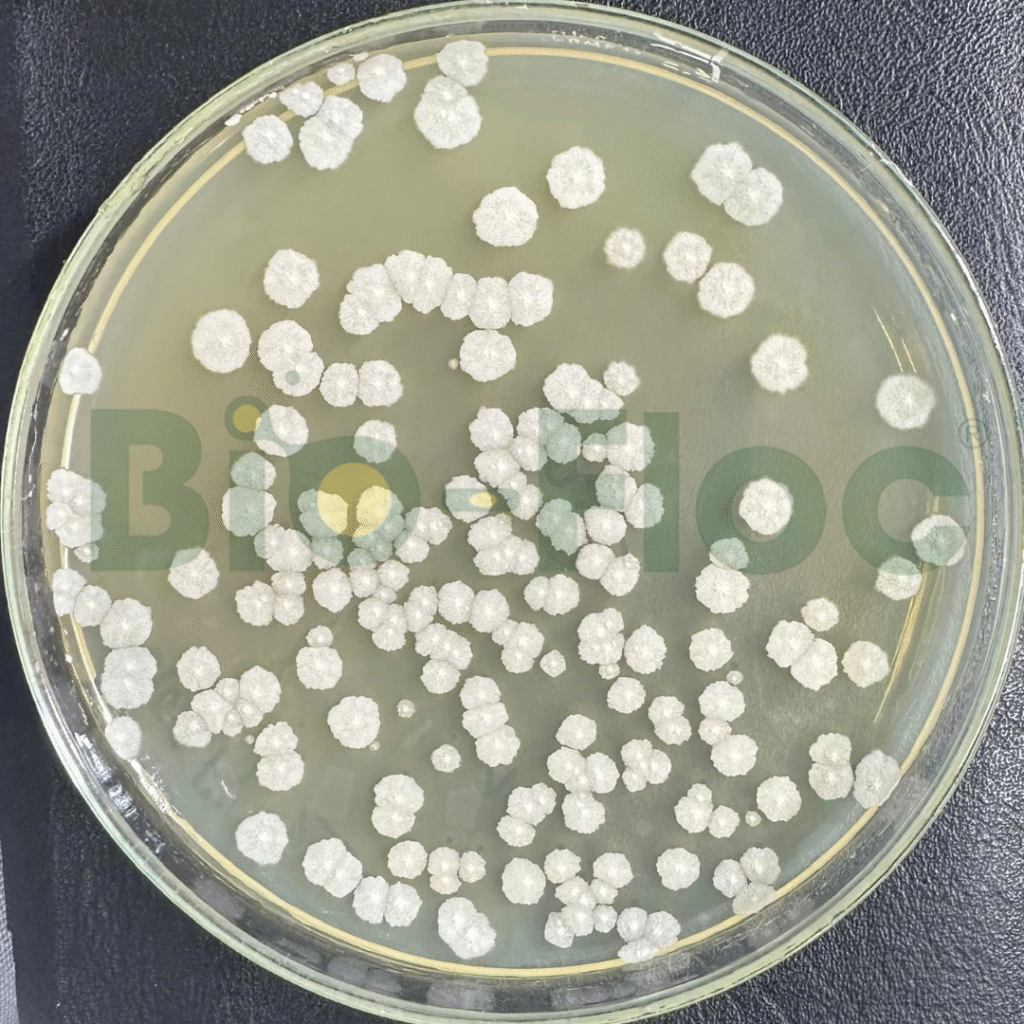
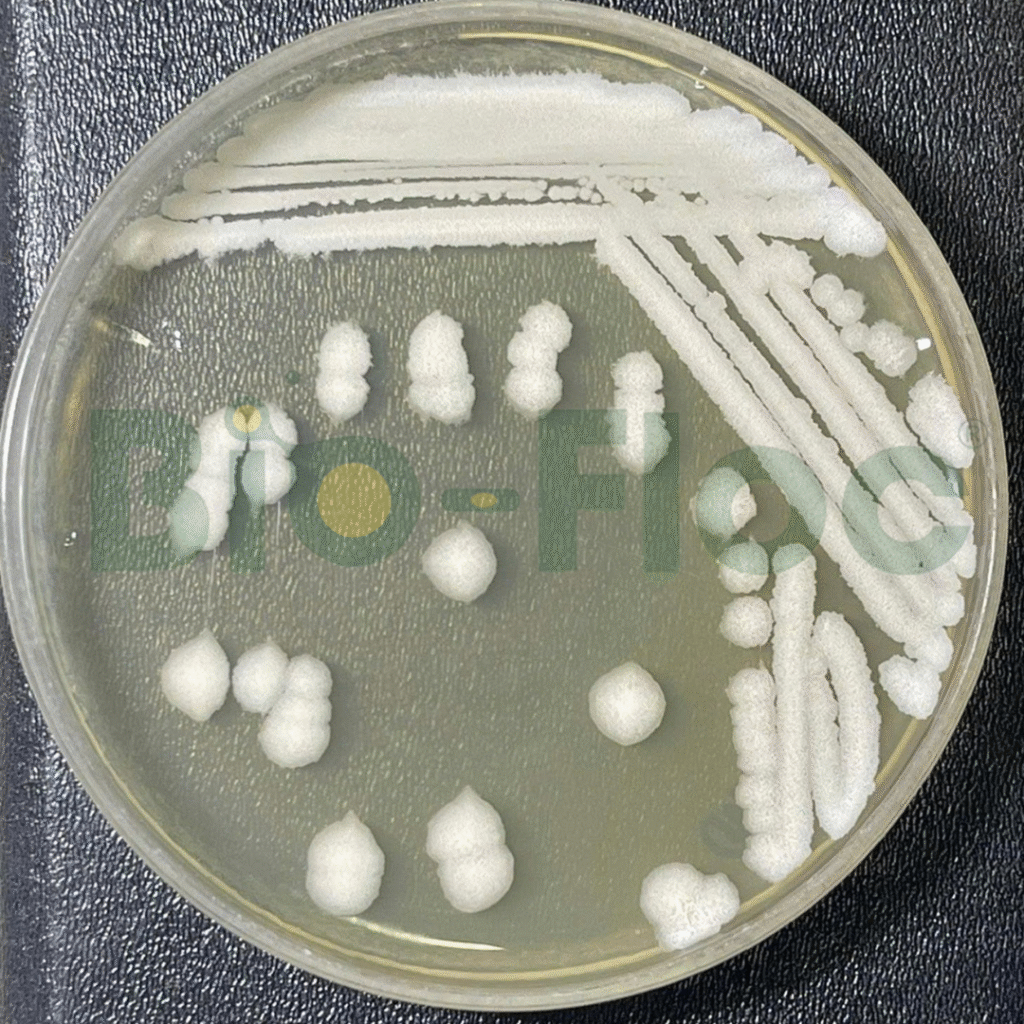
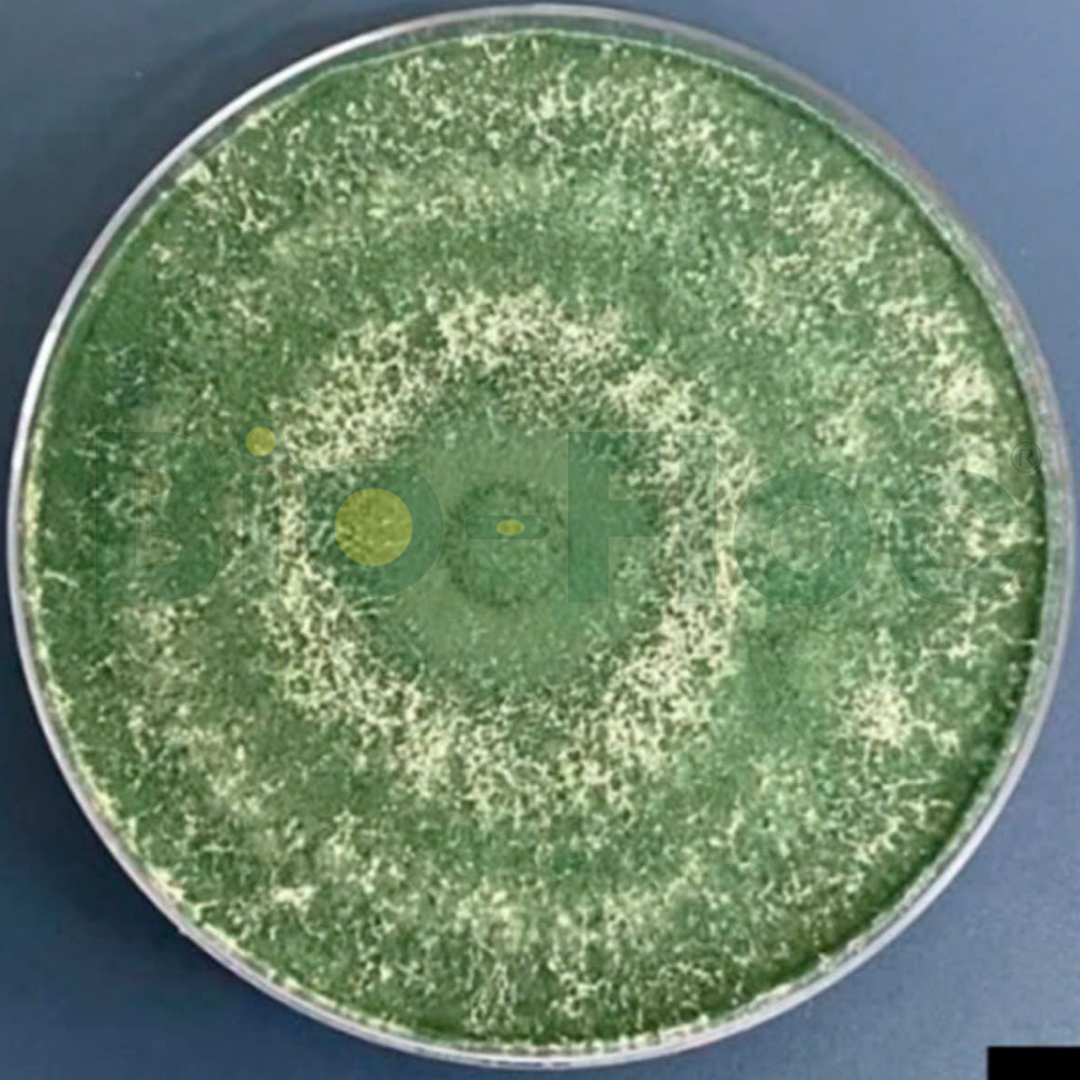
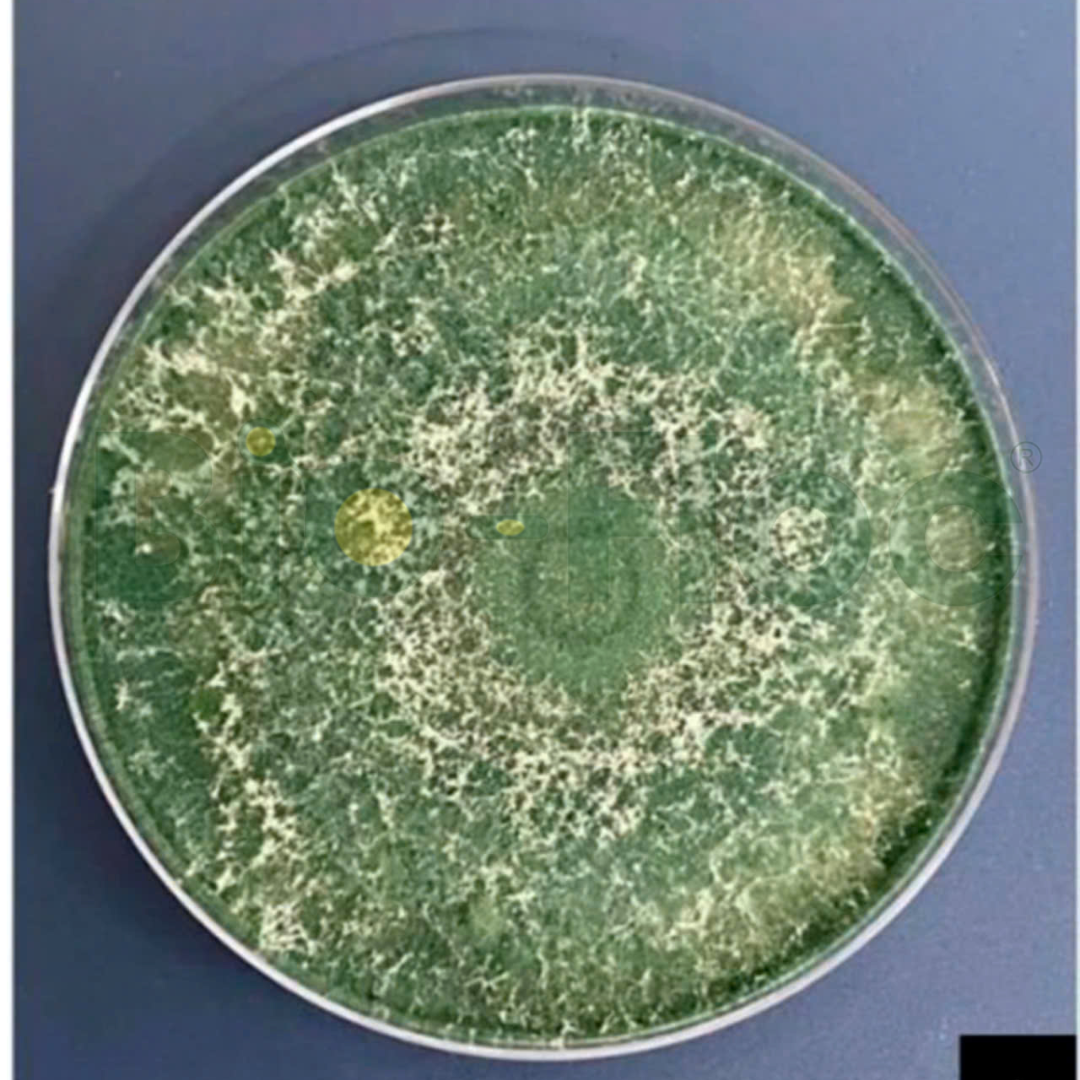

Nguyên liệu vi sinh bản địa cho cây trồng

Vi sinh bản địa
Thích nghi nhanh – nhạy

100% không kháng sinh
An toàn – Hiệu quả

Nhà máy tiêu chuẩn Quốc tế
Đạt tiêu chuẩn ISO 9001:2015


Thích nghi nhanh – nhạy

An toàn – Hiệu quả

Đạt tiêu chuẩn ISO 9001:2015
Bio-Floc là đơn vị tiên phong nghiên cứu – phát triển – cung cấp nguyên liệu vi sinh bản địa chuyên biệt cho cây trồng tại Việt Nam. Giải pháp tối ưu cho các nhà máy, đơn vị sản xuất phân bón hữu cơ, chế phẩm sinh học và nông nghiệp tuần hoàn.

Tại Bio-Floc, chúng tôi phát triển hệ vi sinh vật bản địa phục vụ cây trồng theo hướng thân thiện môi trường, nâng cao năng suất – giảm phụ thuộc hóa học.
Với hơn 13 năm nghiên cứu và sản xuất vi sinh bản địa, Bio-Floc sở hữu bộ chủng giống mật độ cao, hoạt lực mạnh, sẵn sàng cung cấp cho các nhà máy.
– Diệt sâu ăn lá thuộc bộ Lepidoptera trên cây rau (sâu xanh, sâu tơ, sâu khoang)
– Tiêu diệt và ức chế các loại rầy, rệp, sâu ăn lá gặm nhấm
– Có khả năng sinh độc tố trừ sâu.
– Sinh trưởng nhanh, tồn tại được trong điều kiện khắc nhiệt do có khả năng sinh bào tử.
– Có khả năng sinh các enzyme phân giải chất hữu cơ: amylase, cellulase, protease.

– Phân hủy xác bã động thực vật, làm phân vi sinh
– Canh tranh sinh học, ức chế vi khuẩn, nấm bệnh
– Cân bằng hệ vi sinh trong đất, giúp tơi xốp đất
– Khả năng sinh các enzyme phân hủy chất hữu cơ: amylase, cellulase, protease
– Khả năng cạnh tranh dinh dưỡng
– Tiết ra các kháng sinh tự nhiên (bacteriocin), kháng nấm
– Sinh trưởng nhanh, tồn tại được ở điều kiện khắc nghiệt do có khả năng sinh bào tử

– Phân hủy xác bã động thực vật, làm phân vi sinh
– Canh tranh sinh học, ức chế vi khuẩn, nấm bệnh
– Cân bằng hệ vi sinh trong đất, giúp tơi xốp đất
– Khả năng sinh các enzyme phân hủy chất hữu cơ: amylase, cellulase, protease
– Khả năng cạnh tranh dinh dưỡng
– Tiết ra các kháng sinh tự nhiên (bacteriocin), kháng nấm
– Sinh trưởng nhanh, tồn tại được ở điều kiện khắc nghiệt do có khả năng sinh bào tử
Công nghệ sản xuất vi sinh chuẩn ISO – Giải pháp bền vững cho nhà máy nông nghiệp

Bảo quản giống ở nhiệt độ –86 °C. Giúp lưu giữ được các chủng vi sinh bản địa với hoạt tính ổn định trong nhiều năm (lên đến 10 năm) mà không suy giảm

Tăng tỉ lệ cô đặc sinh khối lên 20–50 lần, thu giữ vi sinh cùng enzyme, protein mà không làm tổn thương tế bào, giữ hoạt tính nguyên vẹn

Tối ưu mật độ vi sinh, tính đồng nhất và ổn định giữa các lô sản xuất. Giữ nguyên đặc tính sinh học của từng chủng – không biến dị, không mất hoạt tính

Công nghệ này giúp duy trì tính chất sinh học của sản phẩm, đảm bảo hoạt tính sinh học của các chủng vi sinh, các tế bào vi sinh không bị tổn thương.
Muốn cây trồng khỏe – phải bắt đầu từ hệ vi sinh gốc phù hợp với thổ nhưỡng bản địa. Bio-Floc cung cấp nguyên liệu vi sinh bản địa được phân lập, làm thuần và sản xuất tại Việt Nam, phù hợp với từng vùng đất và cây trồng, giúp nhà máy tối ưu hiệu quả và chi phí.
Mỗi vùng đất có hệ sinh thái vi sinh riêng biệt. Bio-Floc chọn lọc và phân lập các chủng vi sinh mạnh từ đất, nước, rễ cây tại chính khu vực canh tác, đảm bảo khả năng thích nghi và hiệu quả vượt trội.
Không chỉ phân lập, các chủng vi sinh được làm thuần và kiểm nghiệm hiệu lực trực tiếp trên cây trồng tại địa phương – giúp chọn lọc ra những chủng mang lại giá trị rõ rệt.
Tư vấn chọn chủng – thiết kế công thức – phối trộn theo từng loại cây và vùng đất, giúp nhà máy rút ngắn thời gian R&D và tạo ra sản phẩm khác biệt.
Giúp tối ưu sự sống – tối ưu bảo quản – tối ưu vận hành, giúp giữ được mật độ sống cao, đồng đều giữa các lô, dễ phối trộn, phù hợp cho sản xuất quy mô lớn.
Nhờ xuất phát từ tự nhiên và khả năng tương tác cao, nên dễ phối trộn cùng các hoạt chất sinh học khác để tạo ra các công thức sinh học toàn diện cho cây trồng.
Không phụ thuộc nhập khẩu, nguyên liệu vi sinh bản địa của Bio-Floc được nghiên cứu, sản xuất ngay tại Việt Nam, đảm bảo tính ổn định, nhanh chóng và tiết kiệm chi phí.
